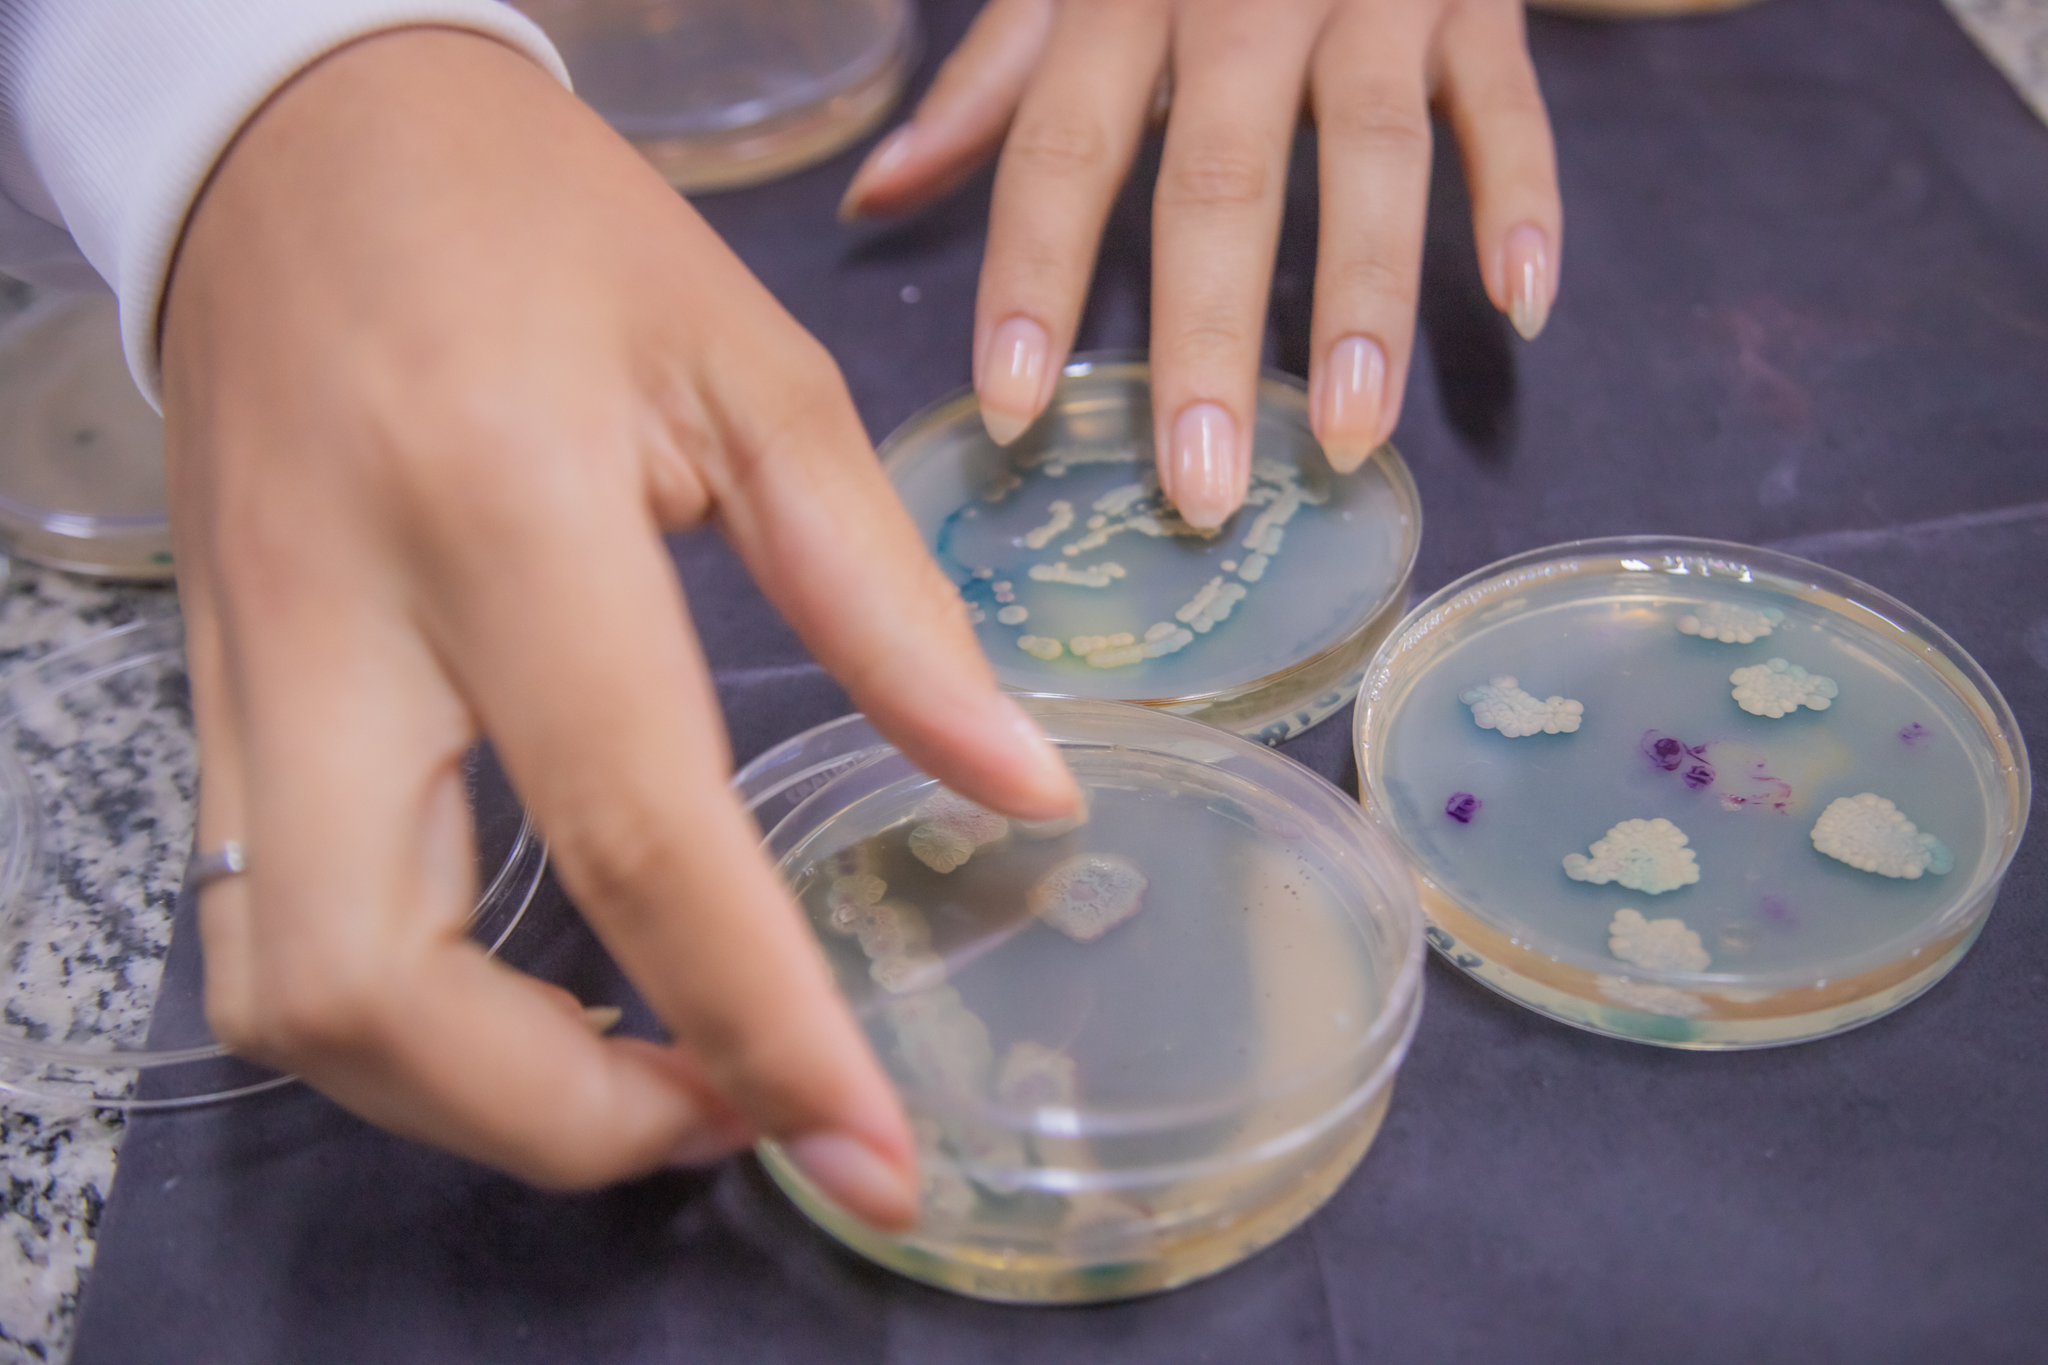

A fotografia é uma paixão que descobri aos poucos. Desde que comecei a fotografar, ainda na época de Universidade, a experiência foi uma verdadeira montanha-russa, onde por muitas vezes me sentia frustrado com o resultado de meu trabalho e em outras tantas-por sorte a maioria; conseguia superar minhas expectativas. Esses pequenos momentos se transformam em histórias, contadas em um frame pela composição da imagem, suas cores, formas, movimentos, sombras e luzes.
CCOM/ UEPG
Produções feitas na cobertura de pautas para a Coordenadoria de Comunicação da Universidade Estadual de Ponta Grossa. Por meio da CCOM UEPG, pude desenvolver olhar fotográfico para diversos temas. Todos os direitos autorais reservados à UEPG.
Cultura e esporte




























Ciência e conhecimento

Retratos humanos










